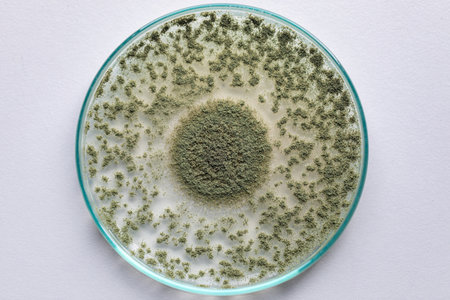
Close up of Aspergillus oryzae is a filamentous fungus, or mold that is used in food production, such as in soybean fermentation for education in laboratory.

Stock photo 1-164121786
Royalty-free photo Close up of Aspergillus oryzae is a...
- Description: Photo by sinhyu. Close up of Aspergillus oryzae is a filamentous fungus, or mold that is used in food production, such as in soybean fermentation for education in laboratory.
- Id: 1-164121786
- Media type: Photos
- Author: sinhyu
- Keywords:
aflatoxin agar allergic allergy amylase amylases ancient antiaging aspergillosis aspergillus aspergillus oryzae colony culture disease enzyme fermentation fermented filamentous fungus flavins food fungi fungus glucoamylase growth health healthy hygiene hyphae infection isolated japan japanese koji laboratory macro material medical microbiology miso mold moldy nutrition organic oryzae rice rotting science starch tradition white
More infos
| Size | Width * Height | MB | Price ($) |
|---|---|---|---|
| Web (jpg) | 848 px * 565 px | 1.37 | 3 |
| Print (jpg) | 2508 px * 1672 px | 12 | 6 |
| Extra large (jpg) | 6720 px * 4480 px | 86.13 | 10 |
| TIFF format (tiff) | 8400 px * 5600 px | 134.58 | 12 |
You are not logged in !
Login in order to download this image.
Incredible stock. Flexible pricing. Buy credits and start downloading today.
Please wait, your image is being downloaded
